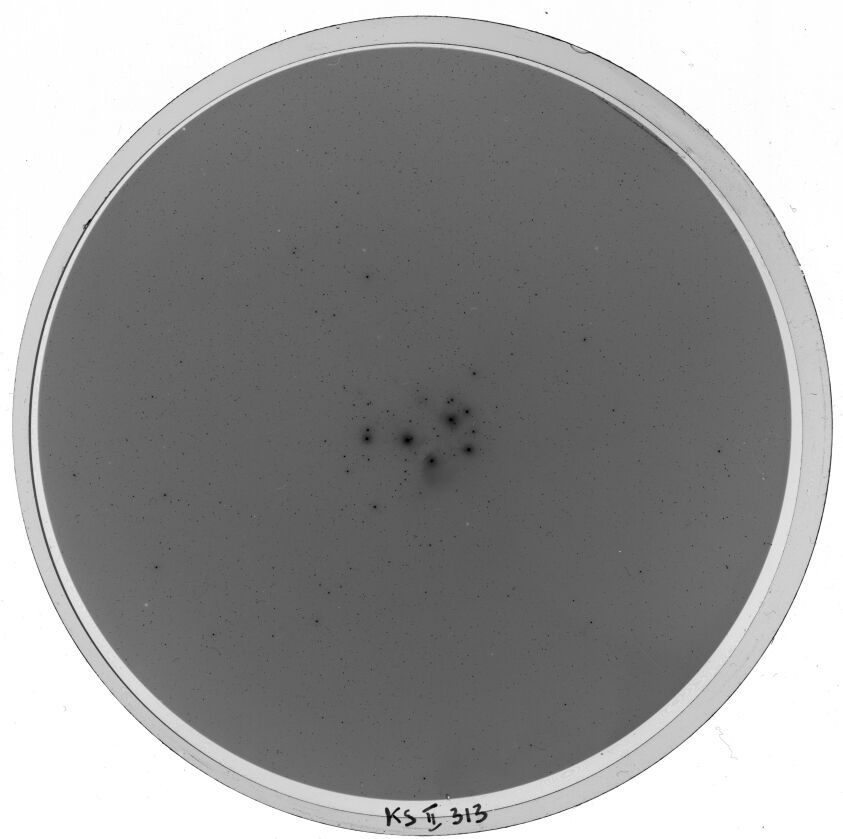

Plate from Kleiner Schmidt-Spiegel II (Hamburg)
Preview
KS00313_pre.jpg

Envelope
(link)

| Applause ID: | dr.3/plates/110_69875 |
| Archive: | Kleiner Schmidt-Spiegel II (Hamburg) |
| Plate number in archive: | KS00313 |
| Institute: | Hamburger Sternwarte |
| Observer name: | Lübeck (1944-??) |
| Observer notes: | |
| Miscellaneous notes: | |
| Bibcode of related paper: | |
| Plate series: | |
| Dispersion: | |
| Plate development information: | |
| Plate quality: | |
| Plate notes: | |
| Plate format: | cifi9 cm |
| Emulsion: | Perutz Phototech. B |
| Original recorded date: | 1957-02-28 |
| Number of exposures: | 1 |
| Observatory name: | Hamburger Sternwarte |
| Observatory site name: | Hamburg-Bergedorf; Germany |
| East longitude of the observing site: | 10.242 deg |
| Latitude of the observing site: | 53.482 deg |
| Elevation of the observatory site: | 41.0 m |
| Clear aperture of the telescope: | 0.36 m |
| Focal length of the telescope: | 0.62 m |
| Plate scale of the telescope: | 330.0 arcsec/mm |
| Instrument name: | |
| Observation filter: | |
| Observation method code (following WFPDB): | |
| Observation prism used: | |
| Used grating: | |
| Air temperature: | |
| Calmness (seeing conditions): | |
| Sharpness: | |
| Transparency: | |
| Notes on sky conditions: |
| Filename scan: | KS00313_x.fits |
| Header file (DR3): | KS00313_x.hdr |
| Length of data axis 1: | 8432 |
| Length of data axis 2: | 8397 |
| Min. value in the image: | 465 |
| Max. value in the image: | 62394 |
| Scanner name: | Epson Expression 10000XL |
| Scanner software: | |
| Scanner gamma value: | |
| Scanner focus: | |
| Resolution of axis 1: | 2400 dpi |
| Resolution of axis 2: | 2400 dpi |
| Pixel size along axis 1: | 10.5833 um |
| Pixel size along axis 2: | 10.5833 um |
| Scan date and time: | May 27, 2015, midnight |
| Author of the scan: | N. Engelhardt |
| Notes about the scan: | |
| Institute responsible for the scan: | Hamburger Sternwarte (Universitaet Hamburg) |
